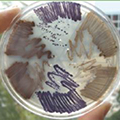
colorful_world_120.jpg colorful_world_120.jpg

Resources
Learn more about our products and services and get the answers, information, and guidance you need to make the best decisions for your classroom. From time-saving product buyers guides to live materials care and delivery information, to chemical safety resources and much more, you’ll find everything you need to shop for and use our hands-on products in our classroom.
Browse resources by subject area or topic below to get started
Your definitive source for hands-on science products and resources for every subject.
Science by You. Directly from your peers.
All the Right Materials for Stocking Your Lab
Helpful resources for your life science and biology classroom.
Download free and easy tools to help you turn science lessons into science connections in your chemistry classroom.
Helpful resources for your earth science and geology classroom.
Helpful resources for your physics classroom.
This valuable resource features Instructional and Informational Literature sheets for the most popular live specimens in our collection.
Need a Safety Data Sheet? Click here to learn how to easily access any SDS documents you need.
Discover serious savings on superior science with our current promotions.
Software, digital content, and convenient kits for hands-on lessons at home.
Boreal Science Custom Kits. Let us build the kits, so you can build the connections.